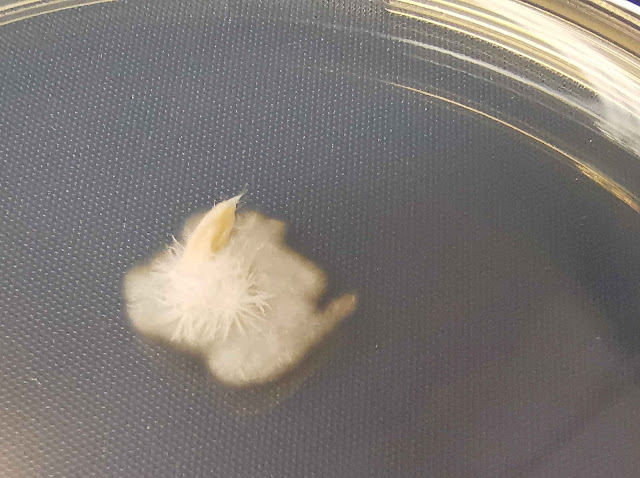
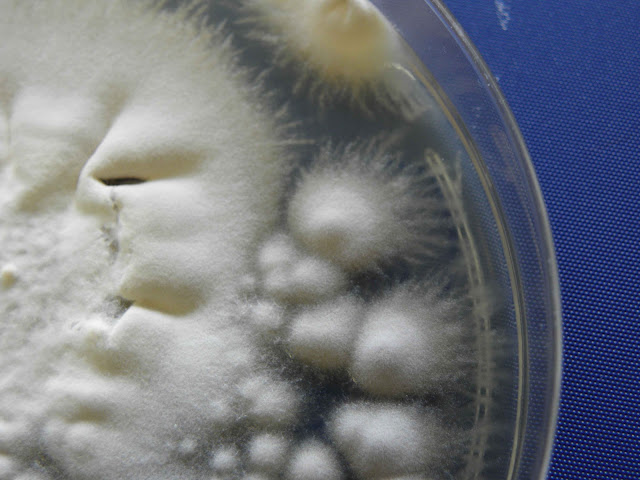

NANNIZZIA FULVA
Nannizzia fulva é um dermatófito geófilo (origem no solo) pertencente ao género Nannizzia, anteriormente classificado como Trichophyton fulvum. É um agente etiológico raro de micoses humanas, mas relevante em contextos específicos.
Patogenicidade
Infecções Humanas
Tinea corporis (corpo): Lesões anulares com borda elevada e escamas.
Tinea capitis (cabelo): Menos comum, pode causar alopecia cicatricial.
Tinea unguium (unhas): Deformação e espessamento das unhas.
Tanto o N. fulva como o N. gypsea são dermatófitos geófilos que podem ocasionalmente causar infecções, principalmente nas mãos ou membros de indivíduos que têm contacto próximo com o solo.
Via de transmissão:
Contato direto com solo contaminado ou material infecioso de animais (ex.: roedores, aves).
Lesões pré-existentes: Corte ou abrasão na pele facilita a entrada do fungo.
Solo fértil: Prefere solos ricos em matéria orgânica, especialmente com
presença de fezes de animais (ex.: morcegos, roedores).
Clima: Regiões tropicais e subtropicais com alta umidade.
Em cultura origina uma colónia plana (2cm ao fim de 7 dias), de cor creme e algodonosa pulverulenta com o passar dos dias; o reverso da colónia é branco ou ligeiramente amarelado mas pode ter pigmento vermelho. Na microscopia observam-se um grande número de macroconídios multisseptados (3 a 6 septos), de paredes rugosas e em forma de barco, e os microconídios podem ser sésseis ou pedunculados, pelo que esta não é uma característica distintiva particularmente útil, mas são geralmente mais em forma de taco. Os macroconídios da N. fulva são muito semelhantes aos de N. gypsea, mas tendem a ser mais finos, com uma relação comprimento/largura de 4,5:1, em comparação com 3,5:1
 |
| Colónia com 8 dias de incubação a 25 C |
 |
| Reverso da colónia. |
 |
colónia com 36 dias de incubação.
|
 |
Várias colónias com 30 dias de incubação.
|
 |
| Reverso da colónia. |
 |
| Microconídeos piriformes e macroconídeos elipsoidais |
 |
| Macroconídeos abundantes |